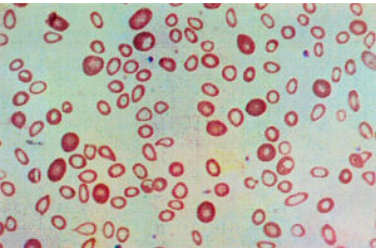
Enunciado 3891547-1

Foram encontradas 1.348 questões.
É o principal marcador bioquímico utilizado para confirmar o infarto agudo do miocárdio. Sua concentração no sangue começa a elevar de 4 a 8 horas após o infarto e volta à concentração normal após cerca de 10 dias, podendo indicar ao médico quando aconteceu o infarto. Marque a alternativa CORRETA, que se refere a esse marcador bioquímico.
Provas
O Ministério da Saúde realizou, no dia 19/06/2024, o webinário Reemergência da coqueluche no mundo. O objetivo é atualizar profissionais de saúde sobre a situação epidemiológica da doença no Brasil e no mundo, além de reforçar as medidas de vigilância e de imunização no país.
Disponível em: https://www.gov.br/saude/pt-br/assuntos/noticias/2024/junho/. Acesso em: 10 ago. 2024.
A coqueluche é conhecida como tosse comprida, transmitida por meio de gotículas eliminadas por tosse, espirro e até mesmo no falar. Trata-se de uma doença infecciosa respiratória causada por uma bactéria chamada
Provas
O teste de fragilidade osmótica mede a intensidade de hemólise dos eritrócitos submetidos às soluções de NaCl em concentrações que variam de 0,1% a 0,9%. Esse teste é específico para anemia esferocítica e pode ser realizado da forma direta ou induzida, sendo que, na forma direta, o sangue deve ser coletado preferencialmente com o anticoagulante:
Provas
Na anemia, ocorre a diminuição da concentração da produção do heme da hemoglobina, por carência de ferro, resultando na diminuição da concentração de hemoglobina. Com a deficiência da hemoglobinização, durante a maturação dos eritroblastos, são formadas hemácias pequenas (VCM diminuído), com pouco conteúdo de hemoglobina (HCM diminuída) e diminuição desproporcional do conteúdo de hemoglobina em relação ao volume de hemácias (CHCM diminuída).
A ilustração a seguir evidencia algumas alterações morfológicas das hemácias:
Disponível em: https://www.ciencianews.com.br/index.php/ciencia/atlas-hematologico/atlas-hematologico-eritrocitos/. Acesso em: 20 jul. 2024. Adaptado.
Com base na ilustração, é CORRETO afirmar que tais alterações são:
Provas
Disciplina: Contabilidade Pública
Banca: COTEC
Orgão: Pref. Montes Claros-MG
Suponha que o responsável pela contabilidade de um município está preparando um contrato de concessão para um serviço público. Com base na Norma Brasileira de Contabilidade Aplicada ao Setor Público (NBC TSP 05) - Contratos de Concessão de Serviços Públicos: Concedente, assinale a alternativa que apresenta os critérios estabelecidos pela NBC TSP 05 para que o concedente reconheça ativos e passivos relacionados a um contrato de concessão de serviços públicos.
Provas
Disciplina: Contabilidade Pública
Banca: COTEC
Orgão: Pref. Montes Claros-MG
De acordo com a NBC TSP 12 - Demonstração dos Fluxos de Caixa -, as entidades do setor público devem preparar e apresentar essa demonstração financeira como parte de suas demonstrações contábeis anuais. Assim, avalie as alternativas a seguir em relação às situações específicas relacionadas aos fluxos de caixa pelo ente público, colocando (V) para verdadeira e (F) para falsa.
( ) Os valores retidos e as consignações em poder de determinado órgão ou entidade devem ser registrados na entidade que detém o controle dos recursos como CEC (grupo de contas do PCASP criado para tal finalidade 1.1.1.3.) em contrapartida ao reconhecimento da obrigação de devolução ou recolhimento no passivo, devendo ser evidenciado em Notas Explicativas.
( ) Os rendimentos das aplicações financeiras de liquidez imediata, classificáveis como equivalentes de caixa; esses acompanham o principal e devem ser registrados de forma a agregar o saldo principal dos valores disponíveis, ou seja, no grupo de contas de CEC.
( ) Os saldos bancários negativos, os cheques especiais, integram as atividades de financiamento e, por isso, esses valores devem ser registrados como obrigação no passivo. Contudo, excepcionalmente, a norma permite que os valores obtidos por cheques especiais ou contas garantidas, que são utilizados e recompostos em curto espaço de tempo, por fazerem parte da gestão de caixa.
A sequência CORRETA, de cima para baixo, é:
Provas
Disciplina: Administração Financeira e Orçamentária
Banca: COTEC
Orgão: Pref. Montes Claros-MG
- Leis OrçamentáriasPPA: Plano PlurianualConceitos Básicos do PPA
- Leis OrçamentáriasPPA: Plano PlurianualPPAs do Governo FederalPPA 2016-2019
O Plano Plurianual (PPA) é um instrumento de planejamento governamental que estabelece, de forma regionalizada, as diretrizes, objetivos e metas da administração pública para um período de quatro anos. Com relação ao PPA, assinale a alternativa CORRETA.
Provas
Disciplina: Administração Financeira e Orçamentária
Banca: COTEC
Orgão: Pref. Montes Claros-MG
Durante o processo de campanha eleitoral, os candidatos a prefeito de certo município se comprometem a priorizar as áreas de saúde e educação, considerando os dados censitários, os indicadores de desempenhos nos rankings estaduais, e também as solicitações da população. Assim, após ser eleito, o prefeito que assumir a gestão municipal, deverá, juntamente com sua equipe, definir: para a área de saúde: metas para atendimento e ampliação de cobertura de serviços nos hospitais e unidades de saúde do município, incluindo a construção de novas unidades; e, para a área de educação: metas para garantir que todas as crianças frequentem uma escola; metas de redução da evasão escolar e melhoria nos índices de desempenho da educação básica; incluindo investimentos em infraestrutura e equipamentos para a rede municipal de ensino. Contudo, para alcançar êxito, o futuro prefeito e sua equipe deverá:
Provas
Disciplina: Administração Financeira e Orçamentária
Banca: COTEC
Orgão: Pref. Montes Claros-MG
Durante o processo de planejamento e elaboração do orçamento anual de um ente público, uma das práticas mais complexas e desafiadoras é a utilização da técnica de orçamento base-zero (OBZ). Analise as afirmativas a seguir e indique qual delas melhor descreve a aplicação adequada dessa técnica no contexto do setor público municipal.
Provas
Disciplina: Contabilidade Geral
Banca: COTEC
Orgão: Pref. Montes Claros-MG
Nos termos da Lei Federal n.º 116, de 31 de julho de 2003, que dispõe sobre o Imposto Sobre Serviços de Qualquer Natureza, de competência dos Municípios e do Distrito Federal, e dá outras providências, o serviço considera-se prestado, e o imposto, devido, no local do estabelecimento prestador ou, na falta do estabelecimento, no local do domicílio do prestador, exceto na seguinte hipótese, quando o imposto será devido no local:
Provas
Caderno Container